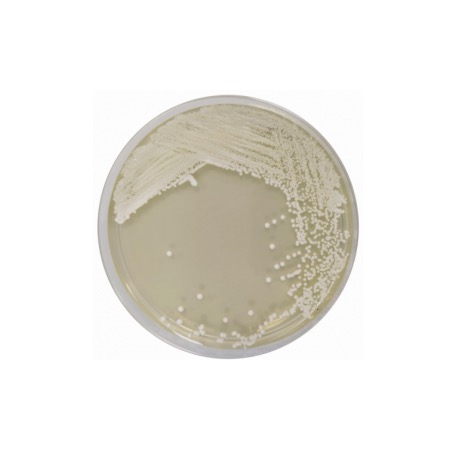

This medium is a modification of the classic Sabouraud Dextrose Agar, featuring a specialized Peptone Mixture (Pancreatic Digest of Casein and Peptic Digest of Animal Tissue) that provides a balanced source of nitrogen, amino acids, and essential vitamins. Dextrose (Glucose) is included at a high concentration to promote the vigorous growth of fungi and yeasts. The addition of Chloramphenicol provides robust selectivity by inhibiting a broad spectrum of Gram-positive and Gram-negative bacteria that may be present in the sample. This formulation meets the stringent requirements for neutralizing potential bacterial interference while maintaining an optimal environment for fungal recovery, facilitating the identification of colonies by their characteristic morphology.
Advantages
- Pharmacopoeia Compliance: Fully compliant with the harmonized requirements of the EP, USP, and JP for the microbiological examination of non-sterile products.
- High Selectivity: The thermostable Chloramphenicol ensures effective suppression of bacterial flora, even in highly contaminated samples.
- Optimized Fungal Recovery: The nutrient-rich base and high carbohydrate content support the rapid development of yeasts and filamentous fungi.
- Standardized Results: Formulated to provide reproducible performance across pharmaceutical, clinical, and cosmetic laboratories.
- Enhanced Visualization: Allows for the clear expression of fungal pigments and colonial structures, aiding in the identification of species such as Candida albicans and Aspergillus brasiliensis.
Technical specifications
| Catalogue number |
1134 |
| Brand |
Condalab |
| Application |
Selective isolation and enumeration of fungi (EP/USP/ISO compliance) |
| Typical Composition (g/L) |
Dextrose (40.0); Peptone Mixture (10.0); Chloramphenicol (0.5); Bacteriological Agar (15.0) |
| Final pH (at 25 °C) |
5.6 ± 0.2 |
| Preparation |
65.5 g/L |
| Storage Temperature |
2 – 25 °C |
Available packaging options
| 1134 |
500 g plastic bottle |

.jpg)